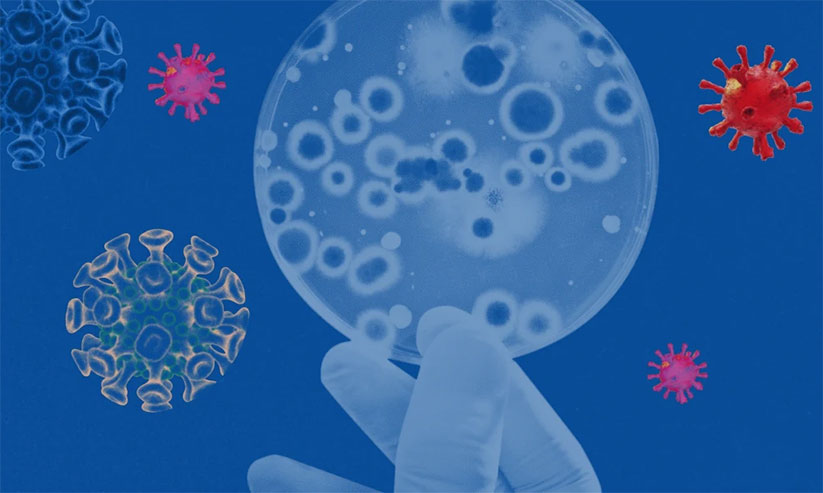

ഒമിക്രോൺ ഭീതിയിൽ ടൂറിസം മേഖല
text_fieldsമട്ടാഞ്ചേരി: കോവിഡ് പ്രതിസന്ധി ശമനമായതോടെ സഞ്ചാരികൾ പുതുവത്സരാഘോഷത്തിന് എത്തുമെന്ന പ്രതീക്ഷയിൽ ഉണർന്ന വിനോദസഞ്ചാര മേഖലക്ക് ഒമിക്രോൺ തിരിച്ചടിയാകുമോയെന്ന് ആശങ്ക. പുതുവർഷം ആഘോഷിക്കാൻ കൊച്ചിയിലെത്താൻ വിദേശ സഞ്ചാരികൾ തയാറായിത്തുടങ്ങുമ്പോഴാണ് പുതിയ ഭീതി ടൂറിസം മേഖലയിൽ ഉടലെടുത്തിരിക്കുന്നത്.
ഇക്കുറി കൊച്ചി മുസ്രിസ് ബിനാലേ ഇല്ലെങ്കിലും കൊച്ചിൻ കാർണിവൽ ആഘോഷവുമായി മുന്നോട്ട് പോകാനുള്ള നടപടികൾ പുരോഗമിക്കുകയാണ്. ഡിസംബർ 31ന് അർധരാത്രിയിലെ പാപ്പാഞ്ഞിയെ കത്തിക്കലും കാർണിവൽ റാലിയും ഒഴിവാക്കി മറ്റുള്ള പരിപാടികൾ നടത്താനാണ് കാർണിവൽ കമ്മിറ്റി തീരുമാനിച്ചിരിക്കുന്നത്.
കാർണിവൽ നടക്കുമെന്ന വിവരം ലഭിച്ചതോടെ വിദേശ, ആഭ്യന്തര സഞ്ചാരികളും കൊച്ചിയിലേക്ക് പുതുവത്സരാഘോഷത്തിന് എത്തുന്നതിനുള്ള ഹോംസ്റ്റേ ബുക്കിങ്ങുകളും ഏറെ പ്രതീക്ഷയാണ് മേഖലയിൽ ഉണർത്തിയത്. ടൂർ ഓപറേറ്റർമാരും സന്തോഷത്തിലായിരുന്നു. ഇതിനിടെയാണ് കോവിഡ് വകഭേദവുമായി ഒമിക്രോൺ പ്രതിരോധ നിയന്ത്രണ ആശങ്ക ഉയർന്നിരിക്കുന്നത്.
ഹോം സ്റ്റേകളിൽ 60 ശതമാനത്തോളം പുതുവത്സരാഘോഷ ബുക്കിങ് നടന്നതായാണ് പറയുന്നത്. ഡിസംബർ രണ്ടാംവാരം മുതൽ ജനുവരി അവസാനം വരെയായി സഞ്ചാരികളെത്തുമെന്ന അറിയിപ്പുകളാണ് ഇവർക്ക് ലഭിച്ചതെന്ന് ഹോംസ്റ്റേ ഉടമകളുടെ സംഘടനയായ ഹാറ്റ്സ് ഭാരവാഹി എം.പി. ശിവദത്തൻ പറഞ്ഞു. ഒന്നരവർഷത്തെ ഇടവേളക്കുശേഷം പ്രതീക്ഷയിൽ ഉണരുന്ന ടൂറിസം മേഖലയെ ഒമിക്രോൺ ഭീതി തളർത്തുമോയെന്ന അങ്കലാപ്പാണ് മേഖലയിൽ ഉടലെടുത്തിരിക്കുന്നത്. രണ്ടുദിവസത്തിനകം ഒട്ടേറെപ്പേർ ആശങ്ക അറിയിച്ച് ബുക്കിങ് മാറ്റിവെച്ചത് മേഖലയിൽ തിരിച്ചടി ഭീഷണി ഉയർത്തിയിട്ടുണ്ട്. ടൂർ ഓപറേറ്റർ മേഖലയിലും ബുക്കിങ്ങുകൾ റദ്ദാക്കിയിട്ടുണ്ട്. സംസ്ഥാനത്തെ വരുമാന മാർഗങ്ങളിലൊന്നായ വിനോദസഞ്ചാര മേഖലയുടെ തളർച്ച സാമ്പത്തിക മേഖലക്കും തിരിച്ചടിയാകും.
Don't miss the exclusive news, Stay updated
Subscribe to our Newsletter
By subscribing you agree to our Terms & Conditions.